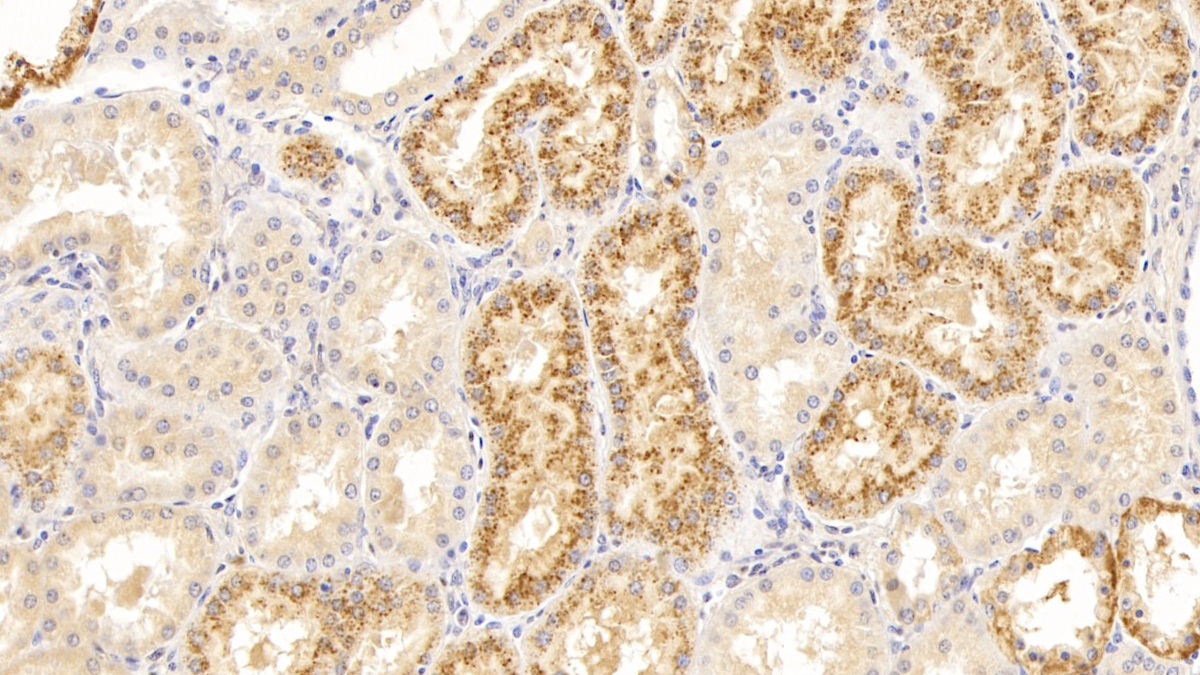
https://d1vffmuvmgkypt.cloudfront.net/image/ridacom_ltd/cloud_clone_corp/PRODUCT_SOURCE__CLOUD_CLONE__SUPPLIER__RIDACOM__ID__PAB193Hu01__1

Antigen
LYZ
Reactivity
Human
(6)
Gallus
(4)
Mouse
(3)
Rat
(3)
Cattle
(2)
Research area
Enzyme & Kinase
(17)
Infection immunity
(11)
Application
Western Blotting
(12)
Immunocytochemistry
(6)
Immunohistochemistry
(6)
Enzyme-linked immunosorbent assay for Antigen Detection
(5)
Positive Control
(5)
SDS-PAGE
(5)
Immunoprecipitation
(4)
ELISA
(2)
Chemiluminescent immunoassay for antigen detection
(1)
IHC-P
(1)
Supplier
Cloud-Clone Corp.
(17)
Abbkine Scientific Co., Ltd.
(1)
Affinity Biosciences
(1)
Test method
Double-antibody Sandwich
(6)
Colorimetric
(1)
Host
Rabbit
(6)
CHO
(1)
Category
Antibodies
(7)
ELISA Kits
(7)
Cell biology
(5)
Immunochemicals
(5)
Protein Biochemistry
(5)
CLIA Kit for Lysozyme (LZM)
$638.00
| 48T | $638.00 | |
| 96T | $912.00 | |
| 96T*5 | $4,104.00 |
| 96T*10 | $7,752.00 | |
| 96T*100 | $63,840.00 |
| 48T | $512.00 | |
| 96T | $732.00 | |
| 96T*5 | $3,294.00 |
| 96T*10 | $6,222.00 | |
| 96T*100 | $51,240.00 |
ELISA Kit for Lysozyme (LZM)
$505.00
| 48T | $505.00 | |
| 96T | $722.00 | |
| 96T*5 | $3,249.00 |
| 96T*10 | $6,137.00 | |
| 96T*100 | $50,540.00 |
ELISA Kit for Lysozyme (LZM)
$505.00
| 48T | $505.00 | |
| 96T | $722.00 | |
| 96T*5 | $3,249.00 |
| 96T*10 | $6,137.00 | |
| 96T*100 | $50,540.00 |
ELISA Kit for Lysozyme (LZM)
$479.00
| 48T | $479.00 | |
| 96T | $684.00 | |
| 96T*5 | $3,078.00 |
| 96T*10 | $5,814.00 | |
| 96T*100 | $47,880.00 |
ELISA Kit for Lysozyme (LZM)
$466.00
| 48T | $466.00 | |
| 96T | $665.00 | |
| 96T*5 | $2,993.00 |
| 96T*10 | $5,653.00 | |
| 96T*100 | $46,550.00 |
Recombinant Lysozyme (LZM)
$192.00
| 10µg | $192.00 | |
| 50µg | $480.00 | |
| 200µg | $960.00 |
| 1mg | $2,880.00 | |
| 5mg | $7,200.00 |
Recombinant Lysozyme (LZM)
$180.00
| 10µg | $180.00 | |
| 50µg | $450.00 | |
| 200µg | $900.00 |
| 1mg | $2,700.00 | |
| 5mg | $6,750.00 |
Recombinant Lysozyme (LZM)
$180.00
| 10µg | $180.00 | |
| 50µg | $450.00 | |
| 200µg | $900.00 |
| 1mg | $2,700.00 | |
| 5mg | $6,750.00 |
Recombinant Lysozyme (LZM)
$160.00
| 10µg | $160.00 | |
| 50µg | $400.00 | |
| 200µg | $800.00 |
| 1mg | $2,400.00 | |
| 5mg | $6,000.00 |
LYZ Antibody
$280.00

Antigen:
Lysozyme C
Synonyms: 1,4-beta-N-acetylmuramidase C; LYSC_HUMAN; P00695; P61626; Q13170; Q9UCF8
Host:Rabbit
Reactivity:Human
Application:Western Blotting; ELISA
Isotype:IgG
Clonality:Polyclonal
Aliases:1 4 beta N acetylmuramidase C; 1; 4-beta-N-acetylmuramidase C; EC 3.2.1.17; LYSC_HUMAN; Lysosyme; Lysozyme (renal amyloidosis); Lysozyme C; Lysozyme C precursor; LYZ; LZM; Renal amyloidosis
| 100μl | $280.00 |
| 200μl | $350.00 |

Antigen:
Host:Rabbit
Reactivity:Cattle
Application:Western Blotting; Immunohistochemistry; Immunocytochemistry; Immunoprecipitation
Clonality:Polyclonal
Research area:Enzyme & Kinase; Infection immunity
| 20µl | $120.00 | |
| 100µl | $280.00 | |
| 200µl | $400.00 |
| 1ml | $1,000.00 | |
| 10ml | $4,000.00 |

Antigen:
Lysozyme C
Synonyms: 1,4-beta-N-acetylmuramidase C; LYSC_HUMAN; P00695; P61626; Q13170; Q9UCF8
Test method:Colorimetric
This gene encodes human lysozyme, whose natural substrate is the bacterial cell wall peptidoglycan (cleaving the beta[1-5]glycosidic linkages between N-acetylmuramic acid and N-acetylglucosamine). Lysozyme is one of the anti-microbial agents found in human milk, and is also present in spleen, lung, kidney, white blood cells, plasma, saliva, and tears. Missense mutations in LYZ have been identified in heritable renal amyloidosis.
| 48T | $260.00 | |
| 96T | $450.00 |
| 96T*5 | $2,025.00 | |
| 96T*50 | $18,900.00 |
| 20µl | $110.00 | |
| 100µl | $256.00 | |
| 200µl | $366.00 |
| 1ml | $915.00 | |
| 10ml | $3,660.00 |

Antigen:
Host:Rabbit
Reactivity:Rat
Application:Western Blotting; Immunohistochemistry; Immunocytochemistry; Immunoprecipitation
Clonality:Polyclonal
Research area:Enzyme & Kinase; Infection immunity
| 20µl | $109.00 | |
| 100µl | $253.00 | |
| 200µl | $362.00 |
| 1ml | $905.00 | |
| 10ml | $3,620.00 |

Antigen:
Host:Rabbit
Reactivity:Gallus
Application:Western Blotting; Immunohistochemistry; Immunocytochemistry; Immunoprecipitation
Clonality:Polyclonal
Research area:Enzyme & Kinase; Infection immunity
| 20µl | $109.00 | |
| 100µl | $253.00 | |
| 200µl | $362.00 |
| 1ml | $905.00 | |
| 10ml | $3,620.00 |
| 10µg | $96.00 | |
| 50µg | $240.00 | |
| 200µg | $480.00 |
| 1mg | $1,440.00 | |
| 5mg | $3,600.00 |

Antigen:
Host:Rabbit
Reactivity:Mouse
Application:Western Blotting; Immunohistochemistry; Immunocytochemistry; Immunoprecipitation
Clonality:Polyclonal
Research area:Enzyme & Kinase; Infection immunity
| 20µl | $103.00 | |
| 100µl | $239.00 | |
| 200µl | $342.00 |
| 1ml | $855.00 | |
| 10ml | $3,420.00 |
Antigen:
Host:Rabbit
Reactivity:Human
Application:Western Blotting; Immunocytochemistry; IHC-P; Immunohistochemistry; ELISA
Clonality:Polyclonal
Research area:Enzyme & Kinase; Infection immunity
| 20µl | $100.00 | |
| 100µl | $232.00 | |
| 200µl | $332.00 |
| 1ml | $830.00 | |
| 10ml | $3,320.00 |




-SCB193Ga-000001.png)



-HEB193Hu-000001.png)



-SEB193Ga-000001.png)



-SEB193Ra-000001.png)



-SEB193Mu-000001.png)



-SEB193Hu-000001.png)


-RPB193Bo01-000001.png)


-RPB193Ga01-000001.png)


-RPB193Mu01-000001.png)
















-PAB193Ga01-000001.png)





-PAB193Mu01-000001.png)



-PAB193Hu01-000001.png)